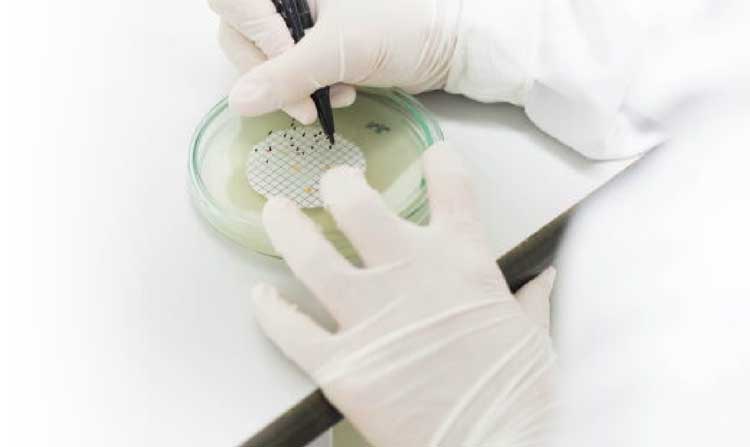

-
Productos
-
Analizadores en línea
Analizadores de la serie EZ
- Alcalinidad
- Hierro
- Aluminio
- Manganeso
- Fosfato
- Cloruro
- Cianuro
- Fluoruro
- Sulfato
- Sulfuro
- Arsénico
- Cromo
- Cobre
- Níquel
- Zinc
- Amonio
- Nitrógeno total
- Fósforo total
- Fenol
- Ácidos grasos volátiles
- ATP
- Dureza
- Toxicidad
- Acondicionamiento previo de muestras
- Boro
- Color
- Nitrato
- Nitrito
- Sílice
- Peróxido de hidrógeno
- Sodium
- EZ Series Reagents
- EZ Series Accesorios
- Serie EZ sc para compuestos inorgánicos
- Serie EZ sc para metales
- Serie EZ sc para nutrientes
- Flujo
- Instrumentos de Laboratorio
- Sondas y Medidores de Laboratorio
- Test Kits y Tiras
-
Microbiología
Medios Preparados
- BARTS
- Filtración por membrana
- Levadura y Moho
- Líquido NMP
- Medio de recuento total
- Paddle Testers
- Presencia-Ausencia
- Tubos MUG
- Equipos y Suministros de Laboratorio
- Piezas de Repuesto
- Industrial UV
- Municipal UV
- Accesorios
- Instrumentos de Hidrología
- Electroquímica
-
Sensores y Controladores en línea
Sensores de Conductividad
- 3400 Analógico de contacto
- 3400 Digital de contacto
- 3700 Analógico inductivo
- 3700 Digital inductivo
- 9523 Conductividad catiónica
- 9525 DCCP System
- SC4500
- Orbisphere 410/510 Carbono Dióxido
- Orbisphere 410/510 Oxígeno
- Orbisphere 410/510 Ozono
- Orbisphere 51x Hidrógeno
- Orbisphere 51x Nitrógeno
- Serie Pro
-
Sustancias Químicas para Laboratorio
Otros Reactivos, Químicos y EstándaresPruebas de Ensayo Preparadas Reactivos en Solución
- Compuestos químicos, reactivos y estándares
- Outlet
-
Analizadores en línea
- INDUSTRIAS
- MARCAS
-
Software
-
Process Management
Gestión de procesos
Retos industriales
Cumpimiento normativo
Reducción de costos
Operaciones remotas
Optimización de procesos
Mantenimiento de equipos
-
Process Management
- Soporte
- Nosotros
- PARÁMETROS
- ¡HAZTE CLIENTE!